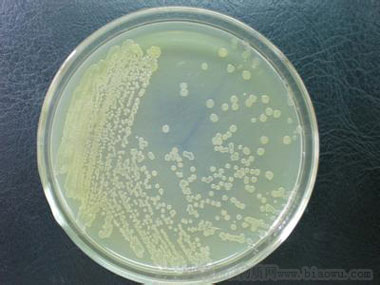
北纳创联嗜氨基氨基杆菌

万千商家帮你免费找货
0 人在求购买到急需产品
- 详细信息
- 文献和实验
- 技术资料
- 保质期:
1-2年
- 供应商:
北纳创联
- 英文名:
Aminobacter aminovorans
| 基本信息 | |
| 资源编号 | BNCC218086 |
| 其它编号 | ACCC10480 |
| 资源名称 | 嗜氨基氨基杆菌 |
| 种属 | Aminobacter aminovorans |
| 提供形式 | 斜面培养物 |
| 安全等级 | 1 |
| 模式菌株 | no |
| 培养方法 | |
| 培养基 | CM0002 |
| 生长条件 | 28C |
| 存储条件 | 真空冷冻干燥 |
| 详细说明 | |
| 描述 | 细胞为两头圆形的杆状,大小为0.5-0.9×1.0-3.0微米,通常单个。细胞运动。革兰氏染色阴性。菌落白色到浅黄色,在营养肉汤和PYG肉汤上生长丰富。不水解洋菜和淀粉。最适生长温度范围300℃-37℃,42℃不生长;在pH6.0-8.0时生长好,高于pH9.0或低于pH5.0不生长。在含3%NaCl培养基上不生长。 |
风险提示:丁香通仅作为第三方平台,为商家信息发布提供平台空间。用户咨询产品时请注意保护个人信息及财产安全,合理判断,谨慎选购商品,商家和用户对交易行为负责。对于医疗器械类产品,请先查证核实企业经营资质和医疗器械产品注册证情况。
文献和实验大肠杆菌亮氨酰-tRNA合成酶E292对于氨基酰化活性的作用
材料 质粒pTrc-99B 大肠杆菌LeuRS 实验步骤 1. 突变体大肠杆菌LeuRS基因的构建 以构建的编码大肠杆菌LeuRS的基因leuS作为模板,利用两步PCR反应扩增得到六个LeuRS变种酶的基因序列(图1)。 第一轮PCR反应的5’和3’引物:引物1和引物4分别具有NcoI和HindIII酶切位点,构建各突变所用的引物如表1所示。PCR反应产物经用NcoI和HindIII
工具 [2] 。用非天然氨基酸整体地扰动生物体的蛋白质组,已被用来在实验中探测基因编码的进化。细菌和噬菌体已适应于非天然氨基酸的掺入,并且为这些进化转变所需要的突变的数量和类型也已经过检验 [ 3~6 ]。 虽然有大量文献涉及细菌在非天然氨基酸环境中的生长(如用色氨酸类似物,见参考文献 [ 7~11 ] ),但其中大部分只是叙述技术,而没有考虑工艺规程的改变怎样影响实验结果。为此,我们在这里提供一些更详尽的方法。2. 材料 ( 1 ) 大肠杆菌菌株 C600 和衍生菌株 C600p。用于转化的菌株
D 型氨基酸氧化酶(DAAO)与过氧化氢检测试剂盒联用,对产物中的 D 型氨基酸的总量进行评价。结果显示只有芽孢杆菌属和类芽孢杆菌属的肠道菌能够产生 D 型氨基酸,且在芽孢杆菌属内,菌株在种和菌株的水平上产 D 型氨基酸的能力也有差异,并与 16S rRNA 相似度没有明显的相关性(图 2),暗示单纯依靠 16S rRNA 测序获得微生物组菌种组成信息,无法准确预测菌群合成 D 型氨基酸的水平。 图 2:DAAO 法评估大鼠肠道菌生产 D 型氨基酸的能力与 16S rRNA 的关系 最后
技术资料暂无技术资料 索取技术资料